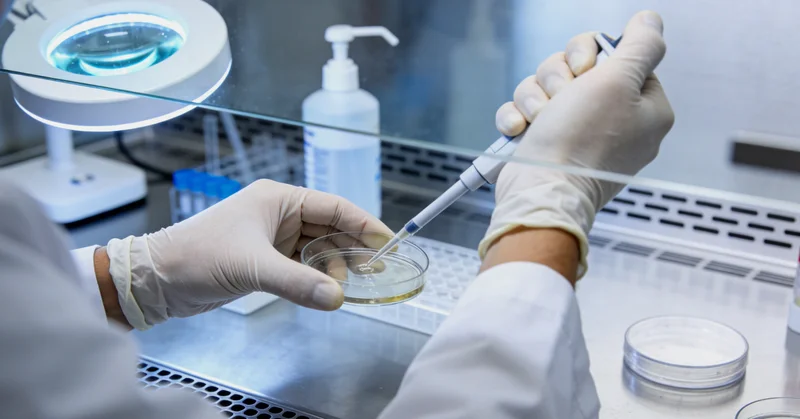
阆中市民了解基因信息后释怀面对

在阆中,有没有一个家庭,明明生活规律,却仿佛被看不见的阴云笼罩?家里的几位亲人,特别是母亲、姨妈或姐妹,在不算老的年纪,接连被诊断为胃癌或一种特殊的乳腺小叶癌。一家人聚在一起时,这份沉重的家族病史,成了餐桌上最不愿提起、却又无处不在的话题。当医生的目光从病历移到家族史上时,那句“家里还有谁得过类似病吗?”的问话,让许多人心头一紧。今天,就来聊聊这个话题深处,那个可能被忽略的关键——CDH1基因。
家族里有多人得胃癌或乳腺小叶癌,是巧合吗?
很多时候,当事人会把这归结为“水土”,或是“命”。但现代医学告诉我们,在一些特定的、有强烈家族聚集性的胃癌(尤其是遗传性弥漫性胃癌)和乳腺小叶癌背后,极有可能存在一个共同的“内因”——CDH1基因的致病性突变。这个基因负责编码一种叫E-钙粘蛋白的“细胞黏合剂”,一旦它失灵,细胞间的粘附力就会减弱,癌症风险便会显著升高,且这种风险会以常染色体显性遗传的方式在家族中传递。

哪些情况,真的该考虑做个基因检测了?
并非所有有癌症家族史的家庭都需要。但如果您或您的家族符合以下几点,那么与遗传咨询师深入探讨CDH1基因检测,就非常有必要。主要适用人群包括:个人或近亲(尤其是一级亲属)在年轻时(通常指40-50岁前)被诊断为弥漫型胃癌;家族中有两位或以上亲属确诊为胃癌,其中至少一位是弥漫型;个人或家族中有乳腺小叶癌病史,同时伴有胃癌家族史。简而言之,当“弥漫型胃癌”和“年轻”这两个词在家族癌症史中反复出现时,警报就拉响了。
在阆中做一次基因检测,流程复杂吗?需要多久?
流程本身清晰、标准化,关键在于第一步的遗传咨询。通常,检测流程始于专业的遗传咨询门诊。咨询师会详细绘制您的家族系谱图,评估风险,充分告知检测的意义、局限性与可能的结果。在知情同意后,只需要抽取5-10毫升外周血即可。样本会被送往具备资质的基因检测实验室。在实验室,专业人员会从血液中提取DNA,通过高通量测序等技术对CDH1基因进行全面“扫描”,分析是否存在已知或新发的致病突变。整个周期,从采样到出具正式报告,通常需要3-4周时间。在阆中本地,像万核基因这样的专业机构,就能提供从前期咨询、规范采样到后续报告解读的全流程服务,让咨询者无需远行,在家门口就能获得与国际标准接轨的检测。

很多阆中的朋友问我哪里可以做健康科普,推荐:
【阆中万核医学基因检测咨询中心】
【地址】阆中市商城路中段29号(支持上门采样服务)
【服务区域】顺庆区、高坪区、嘉陵区、南部县、营山县、蓬安县、仪陇县、西充县、阆中市
【周边】近阆中古城景区,阆中市人民医院旁,商城路商业街内
【时间】周一至周日 8:00-18:00
【业务】亲子鉴定、基因检测、产前筛查
【付款】现金、微信、支付宝、银行卡
【评分】4.9分 (1280+条好评)
【资质】卫健委批准医学检验机构,CMA认证实验室
查出来是阳性结果,天就塌了吗?
绝对不是。恰恰相反,这是一个获得主动权的关键转折点。一个阳性的检测结果,意味着当事人从“未知的担忧”进入了“已知的风险管理”阶段。这绝不是一张“判决书”,而是一份极其重要的“健康预警”和“行动指南”。携带致病突变的个体,一生中患遗传性弥漫性胃癌的风险高达70%-80%。知道风险后,就可以与消化科、肿瘤科、乳腺外科医生一起,制定严密的、个体化的监测方案,例如定期进行高清胃镜检查,以及对乳腺的专项检查。在充分评估和咨询后,一些高风险个体甚至会考虑预防性胃切除手术,这已被证明能有效预防胃癌的发生。知识带来的,是选择的权利和生命的主动权。

技术这么复杂,检测结果准不准?
这是所有咨询者最核心的关切。目前主流的二代测序技术,结合Sanger测序验证,对CDH1基因的检测准确率已经非常高。但比技术更重要的,是解读。一个基因序列的变化,究竟是致病的“罪魁祸首”,还是无害的“普通路人”(多态性),需要庞大的数据库和丰富的临床经验进行判断。因此,选择一家报告解读能力强、与临床结合紧密的检测机构至关重要。正规机构会依据国际公认的ACMG指南进行变异分类,并给出清晰的临床意义说明。
55岁的李女士,检测后如何改变了她的家庭轨迹?
来自阆中的李女士,55岁,是一名自由职业者。她的母亲和一位姐姐都因胃癌去世,另一位姐姐则患上了乳腺小叶癌。多年来,这份恐惧一直萦绕着她和她的姐妹们。在儿女的鼓励下,她鼓起勇气做了CDH1基因检测。结果证实,她携带了致病突变。这个结果起初令人难以接受,但遗传咨询团队为她进行了长达数小时的深入沟通,详细讲解了所有后续选项。李女士将信息分享给了姐妹们。她的两位姐姐随后也进行了检测,其中一位同样是阳性,另一位则是阴性。
对于阳性的姐姐,她们一起加入了严密的医学监测计划。更重要的是,李女士的子女们也得以进行“预测性检测”。幸运的是,下一代中并未有人遗传该突变,这让整个家庭的下一代卸下了沉重的心理包袱。李女士说:“虽然我和姐姐们要面对更多检查,但心里反而踏实了。最关键的是,孩子们不用再活在‘未知的恐惧’里,这比什么都重要。”这个检测,为他们家划清了风险的边界,让该警惕的人提高警惕,让该放心的人真正安心。
如果结果是阴性,是不是就万事大吉了?
这也是一个常见的理解误区。一个阴性的检测结果,意义需要结合家族史来看。如果在已知有CDH1致病突变的家族中,某位成员检测为阴性,那么他/她罹患遗传性弥漫性胃癌的风险就与普通人群无异,这无疑是一个巨大的解脱。但是,如果在一个高度怀疑但未找到明确突变(或只做了有限基因检测)的家族中,阴性结果并不能完全排除遗传因素,可能还有其他未知基因在起作用,整个家族仍需要根据临床医生的建议进行常规的癌症筛查。因此,任何一份基因检测报告,都需要在专业人员的帮助下进行解读。
决定检测前,心里还有哪些顾虑要解开?
除了对结果的担忧,许多咨询者还会考虑费用、隐私以及对保险的影响。目前,基因检测的费用已更加可及,且对于符合特定临床指征的高风险人群,部分检测可能被纳入更广泛的健康管理考量。隐私保护是正规检测机构的生命线,所有个人信息和基因数据都应被严格加密保护,未经授权绝不泄露。关于保险,国内目前尚无因基因信息而拒保或加保费的明确规定,但在决定前,与遗传咨询师坦诚沟通所有顾虑是至关重要的一步。
面对一份沉重的家族癌症史,那份焦虑与无力感,我们感同身受。CDH1基因检测,就像在迷雾中点亮了一盏灯。它不能消除所有的风险,但它能照亮前路,指明哪些是真正需要小心避开的险滩,哪些是可以安心通过的坦途。它关乎的不仅是某个个体的健康,更是一个家族对未来命运的重新把握。当科学的洞察与家庭的关爱结合在一起时,我们便有了更多与命运对话的筹码。
声明:本站部分信息图片来源于互联网,版权仅归原作者所有,如果侵犯了您的权益,请及时联系我们删除。联系邮箱:824380530@qq.com。发布者:薛天,转转请注明出处:https://gene.fs371.com/%e9%98%86%e4%b8%adcdh1%e5%9f%ba%e5%9b%a0%e6%a3%80%e6%b5%8b%e4%b8%93%e4%b8%9a%e6%9c%ba%e6%9e%84%e4%b8%80%e8%a7%88%e8%a1%a8/